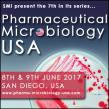

CORRECTION - Dynagas LNG Partners Announces Date for the Release of First Quarter 2017 Results, Conference Call and Webcast
MONACO--(Marketwired - May 22, 2017) - In the news release, "Dynagas LNG Partners Announces Date for the Release of First Quarter 2017 Results, Conference Call and Webcast," issued earlier today by Dynagas LNG Partners LP (NYSE: DLNG), we are …